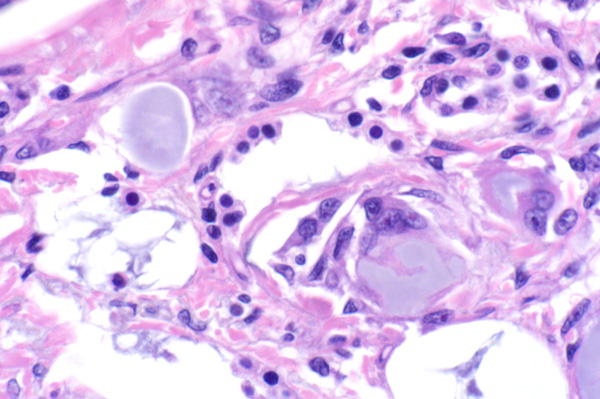

| 40x | Hematoxylin and Eosin | ||||
| Close Window | Macro View | Show Help | Back | |
|
Multinucleated cells surround amorphous material. There is type II pneumocyte hyperplasia (arrows).
|
||||

|
||||
| Return | ||||
|
Multinucleated cells surround amorphous material. There is type II pneumocyte hyperplasia (arrows).
|
||||